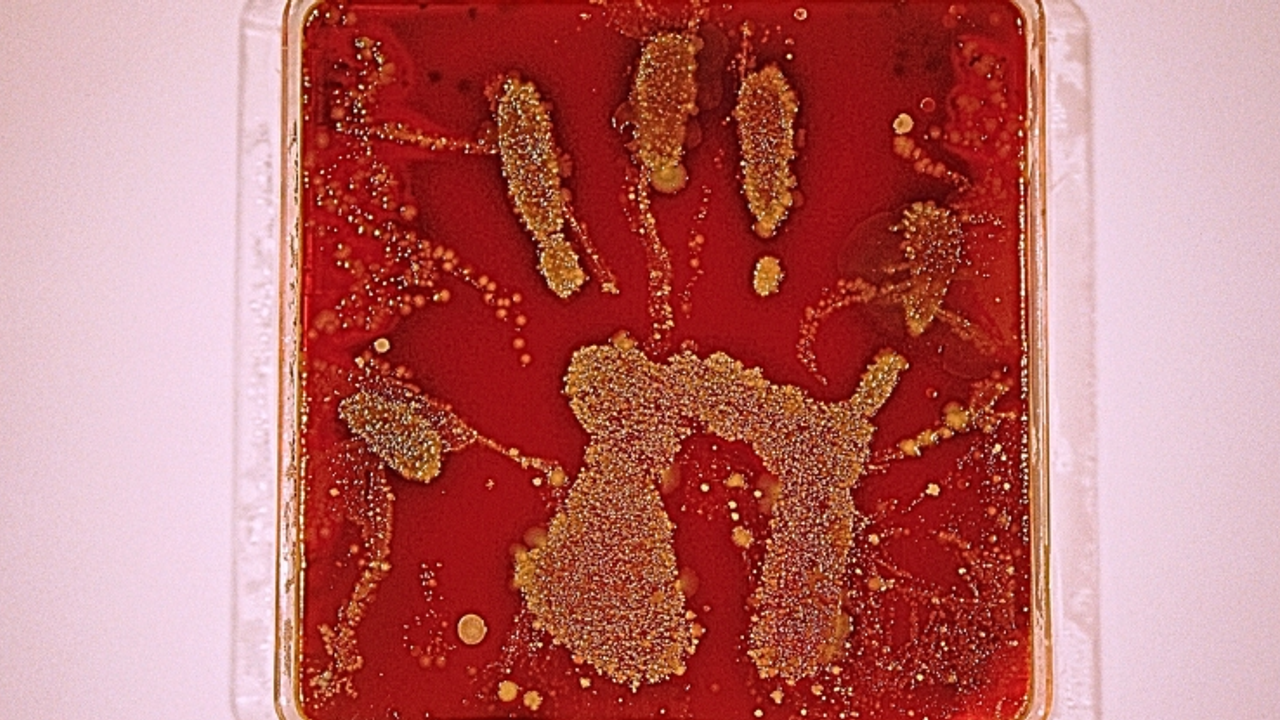

Güneşin tadını çıkardığımız, açık havada geçirilen uzun günler, festival alanlarında danslar ve gökyüzü altında kurulan sofralar… Yaz mevsimi, enerjisiyle insanı içine çeken bir dönem. Ancak tüm bu güzelliklerin gölgesinde çoğu zaman göz ardı edilen bir risk var: enfeksiyonlar.
Sıcak hava, artan sosyal etkileşim ve farklı ortamlara daha sık girip çıkmak, mikropların yayılmasını kolaylaştırıyor. Bu nedenle yaz aylarında el yıkama alışkanlığı her zamankinden daha kritik hale geliyor.
Mikroplar sıcak ve nemli ortamlarda hızla çoğalır. Yaz aktiviteleri ise bizi sık sık mikropların bulunabileceği yüzeyler, yiyecekler ve su kaynaklarıyla temas ettirir.
KAMUSAL TUVALETLER VE ORTAK ALANLAR
Plajlar, festivaller, otoyol dinlenme tesisleri ve kamplar gibi yerlerde kullanılan umumi tuvaletler, E. coli, salmonella ve Staphylococcus aureus gibi bakterilerin üreme noktası olabilir. Norovirüs, grip ve hatta koronavirüs gibi virüsler de bu alanlarda kolayca yayılır.
Yeni bir 2025 çalışması, hastanelerde bile tuvaleti kullandıktan sonra ziyaretçilerin neredeyse yarısının ellerini yıkamadığını ortaya koydu. Hastane gibi riskin net olduğu yerlerde durum buysa, yaz festivallerinde ya da kamplarda el yıkamanın ne kadar ihmal edildiğini tahmin etmek zor değil.
AÇIK HAVADA YEMEK VE YİYECEK HAZIRLAMA
Mangal ve piknikler yazın vazgeçilmezidir ancak gıda kaynaklı hastalıkların da başlıca sebepleridir. Salmonella, E. coli, Bacillus cereus ve Staphylococcus aureus sıcak havada hızla çoğalır. Az pişmiş et, yetersiz el hijyeni ve güneşte bekleyen yiyecekler, kısa sürede gıda zehirlenmesine yol açabilir.
Ayrıca Aspergillus gibi mantarlar yiyeceklerde üreyerek mide bulantısı, organ hasarı veya uzun vadeli sağlık sorunlarına yol açabilen mikotoksinler üretebilir. Bu nedenle yiyecekle temas öncesi ve sonrası eller mutlaka yıkanmalıdır.
YÜZME, SU OYUNLARI VE PLAJ
Göller, nehirler, denizler ve havuzlar zararlı mikroplar barındırabilir. Cryptosporidium ve giardia gibi parazitler ishal ve mide rahatsızlıklarına neden olur; üstelik çoğu klora dirençlidir. Plaj kumu ve deniz suyu da dışkı kaynaklı bakteriler taşıyabilir.
Denizde yüzdükten ya da kumda oynadıktan sonra yemek yemeden önce mutlaka ellerin temizlenmesi gerekir.
KAMPLAR, OYUN ALANLARI VE FESTİVALLER
Çocuklar yazın toplu etkinliklerde enfeksiyonlara karşı daha hassastır. ABD’de yapılan bir araştırma, 7 yılda gençlik kamplarında 229 gastroenterit salgını yaşandığını ortaya koydu.
Bir vakada, kamp ateşinde az pişmiş et yiyen 20 çocuk hastalanmış, üçü hastaneye kaldırılmıştı. Paylaşılan tuvaletler, toplu yemek hazırlığı ve yakın uyuma düzenleri, el hijyeninin önemini kat kat artırıyor.
“BİRAZ KİR İYİDİR” İNANCI GERÇEĞİ YANSITMIYOR
Bazı kişiler, çocukların kirlenmesinin bağışıklığı güçlendireceğini düşünür. Doğadaki mikroplara maruz kalmak bağışıklık sistemine katkı sağlayabilir ancak bu, tuvalet sonrası ya da yemek öncesi el yıkamamak anlamına gelmez.
Ellerin yıkanmaması bağışıklığı güçlendirmez; aksine hastalık riskini artırır. Özellikle küçük çocuklar, yaşlılar ve bağışıklığı zayıf kişiler için risk daha yüksektir.
YAZDA HİJYENİN ALTIN KURALI: 20 SANİYE KURALINA UYUN
El yıkamak basit, ucuz ve etkili bir korunma yöntemidir. Eller, sabun ve temiz akan suyla en az 20 saniye yıkanmalı, ardından iyice kurulanmalıdır. Sabun ve su yoksa en az yüzde 60 alkol içeren el dezenfektanı kullanılmalı ve mümkünse çantada bulundurulmalıdır.